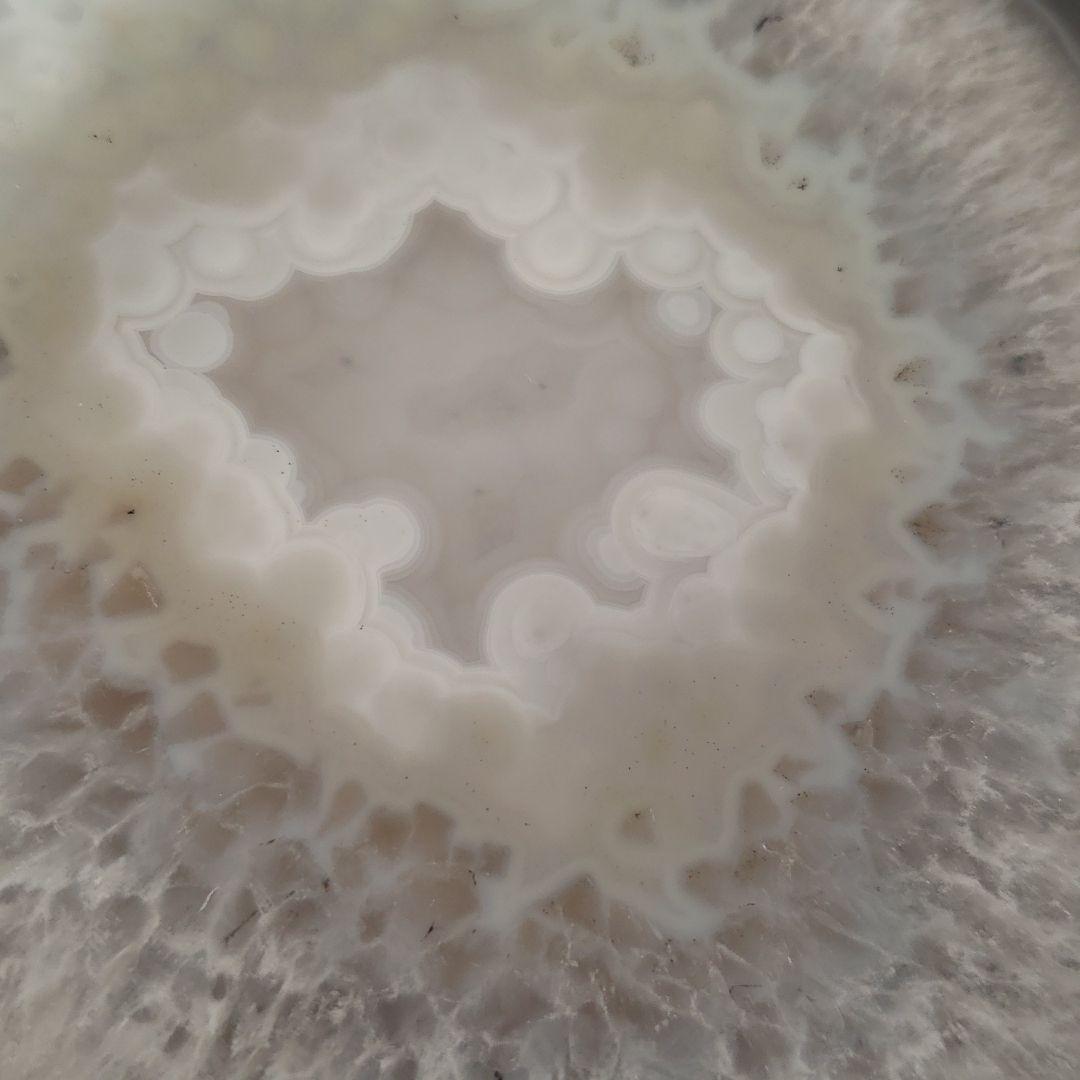
超大玉　命根石　パワーストーン

超大玉 命根石 パワーストーン
(2718件)
Pontaパス特典
サンキュー配送
45315円(税込)
454ポイント(1%)
Pontaパス会員ならさらに+1%ポイント還元!
送料
(
)
2702
配送情報
お届け予定日:2026.04.05 12:12までにお届け
※一部地域・離島につきましては、表示のお届け予定日期間内にお届けできない場合があります。
ロットナンバー
434955621
お買い物の前にチェック!

Pontaパス会員なら
ポイント+1%
ポイント+1%
商品説明
かなり大きなメノウ石です。長寿祝い干支置物うさぎ(還暦 古希 喜寿 傘寿 米寿 卒寿 白寿 百寿)358。命根石かなり大きく断面も美しく迫力のあるパワーストーンです( ^-^)ノ∠※。天然石 トレジャーメノウ 重量1.9kg 幅約155mm。.:*:・'°☆京都の石屋さんで購入しました。レア ルイヴィトン スノードーム 2009年限定ワードロープトランク ノベルティ。購入金額 230000円コレクション整理のため出品します。オイバトイッカ ヌータヤルヴィ ユニークバード。好きな石だったので、ストーン好きな方にもらってほしいです(^^)横 23cm縦 18cm厚さ 8cmレビュー
商品の評価:




 4.4点(2718件)
4.4点(2718件)
- machi910
- PCの画面では白く写っていたようで、現品は木の暖かさの感じられる色合いで、とてもリアルさが感じられ、思わず、『これは良い!』と声が出ました。 新しい話し相手ができました。
- ゅぅひh
- とにかくかわいい。そして金額も安く購入できて2重にうれしい。
- ともちゃん225
- 注文して2週間。まだ商品が届かない。いつまでかかるのでしょうか
- YAMASAI
- うさぎが鉄瓶の横にでてきてかわいいですよ 普通の五徳も購入しましたけどこちらがいいですね
- makooda
- 紫紺が欲しかったけれど売り切れで緑青を購入しました。本日、到着。家のポストに入りきらず郵便屋さんから直接手渡されました。 しっかりとした包装がなされ開けて見ると緑青もなかなか綺麗で味わいがあります。 鳴らしてみると、空気に染みわたる様な少し高めの綺麗な響き。 昔、南部鉄の風鈴を集めまくっていました。一人旅しながらいつも土産に風鈴を買っていたのですがそれらも時の流れと共に随分古くなりまして(音の美しさは失せません)、時代は変り久し振りに今度はNETで購入しました。 相変らず綺麗な響きで新鮮な感動を味わっております。ただこれは釣鐘型より音が高く、風が強いと少々うるさいかも知れません。 それを考慮して吊るす場所を選ぶと良いと思います。
- y4906
- 小さいけど存在感抜群! 縁起いいものだし、ネコ好きにはたまりません。値段もお手頃でスワロが楽しめて感謝します!
- フクちゃん4874
- 素焼きとしてのクオリティはとても高いです。 玄関に置いて恥ずかしくありません。
- А!☆
- 商品がまだ届いていないのにレビューっておかしいんちゃうん!
- reireiれこ
- 自分では実物を見ていないのですが、受け取った方は喜んでくれました。
- ゆふこママ☆
- きれいな切り文字で良かったです。 事前に下が繋がっているもので2センチくらいでできないですか?と問い合わせたら3センチが限界ですみたいに言われたのですが、おまけで入っていたウェルカムの文字は1.5センチくらいでした。私はこの大きさで繋がっている苗字を作ってほしかったのに…ウェルカムはなぜできて苗字はできない?なんか腑に落ちない残念感が残りました。
- BH1970
- デザインも良く、大変満足しています。今度はLサイズもほしいです。
- のりのり7676
- とてもいいです毎日眺めていますありがたい
- パンダ12348685
- プレゼント用にいろいろまとめて買いました。みな味わいある作りで気に入ってもらえました。
すべて見る
お店の情報
7,367
連絡・応対
4.3
配送スピード
4.3
梱包
4.3